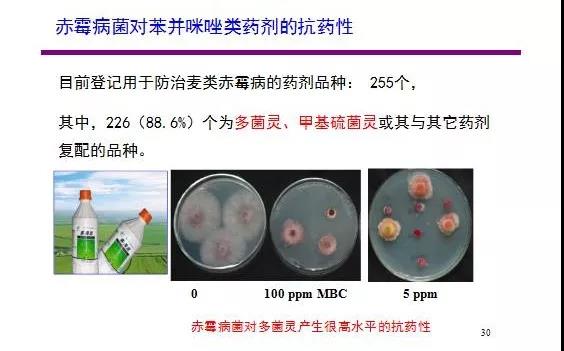

小麥赤霉病別名麥穗枯、爛麥頭、紅麥頭,是小麥的主要病害之一。小麥赤霉病在全世界普遍發生,主要分布于潮濕和半潮濕區域,尤其氣候濕潤多雨的溫帶地區受害嚴重。從幼苗到抽穗都可受害,主要引起苗枯、莖基腐、稈腐和穗腐,其中為害最嚴重的是穗腐。
典型病狀


枯穗癥狀由頂部向下發展


病菌分離【培養】



稻樁、玉米桿上赤霉病菌子囊殼


淮安市農科院種植的淮南片99個國家區試品種病穗率都在80%以上



當前,在農業部獲得防治麥類及小麥赤霉病登記的藥劑共299個(截止2017年3月)。
| 農藥名稱 | 登記證件個數 | 備注 |
| 多菌靈 | 165個 |
其中93個登記證為多菌靈單劑;35個登記證為多·酮,剩余為多菌靈與其它制劑的混配登記證 |
|
甲基硫菌靈 |
72個 |
其中55個登記證為甲基硫菌靈單劑,剩余為甲基硫菌靈混劑登記證 |
|
福美雙 |
37個 |
福美雙單劑登記證 |

防治赤霉病要掌握好防治時期,若抽穗期遇到連陰雨,有流行可能時,噴藥時間寧早勿晚,在10%小麥抽穗至揚花初期進行第一次噴藥,間隔5-7天,進行第二次用藥。噴藥時要重點對準小麥穗部均勻噴霧,如遇噴藥后下雨,則需雨后補噴。

來源:公益植保
下一篇:小麥后期管理高產關鍵技術